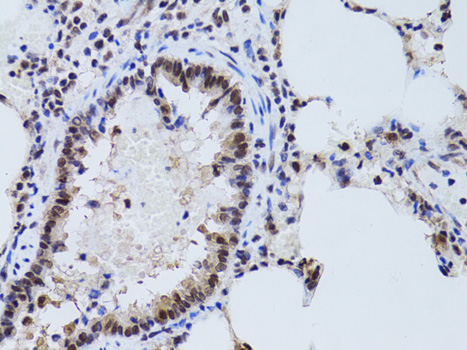
Immunohistochemistry - SIRT7 Polyclonal Antibody

-
Product Name
SIRT7 Polyclonal Antibody
- Documents
-
Description
Polyclonal antibody to SIRT7
-
Tested applications
WB, IHC, IF
-
Species reactivity
Human, Mouse, Rat
-
Alternative names
SIRT7 antibody; SIR2L7 antibody; sirtuin 7 antibody
-
Isotype
Rabbit IgG
-
Preparation
Antigen: Recombinant fusion protein containing a sequence corresponding to amino acids 201-400 of human SIRT7 (NP_057622.1).
-
Clonality
Polyclonal
-
Formulation
PBS with 0.02% sodium azide, 50% glycerol, pH7.3.
-
Storage instructions
Store at -20℃. Avoid freeze / thaw cycles.
-
Applications
WB 1:500 - 1:2000
IHC 1:50 - 1:200
IF 1:50 - 1:200 -
Validations

Western blot - SIRT7 Polyclonal Antibody
Western blot analysis of extracts of various cell lines, using SIRT7 antibody at 1:1000 dilution.Secondary antibody: HRP Goat Anti-Rabbit IgG (H+L) at 1:10000 dilution.Lysates/proteins: 25ug per lane.Blocking buffer: 3% nonfat dry milk in TBST.Detection: ECL Enhanced Kit .Exposure time: 90s.
Immunohistochemistry - SIRT7 Polyclonal Antibody
Immunohistochemistry of paraffin-embedded rat lung using SIRT7 antibody at dilution of 1:100 (40x lens).

Immunohistochemistry - SIRT7 Polyclonal Antibody
Immunohistochemistry of paraffin-embedded human vermiform appendix using SIRT7 antibody at dilution of 1:100 (40x lens).

Immunohistochemistry - SIRT7 Polyclonal Antibody
Immunohistochemistry of paraffin-embedded mouse heart using SIRT7 antibody at dilution of 1:100 (40x lens).

Immunofluorescence - SIRT7 Polyclonal Antibody
Immunofluorescence analysis of HeLa cells using SIRT7 antibody . Blue: DAPI for nuclear staining.
-
Background
NAD-dependent protein deacetylase that specifically mediates deacetylation of histone H3 at 'Lys-18' (H3K18Ac). In contrast to other histone deacetylases, displays selectivity for a single histone mark, H3K18Ac, directly linked to control of gene expression. H3K18Ac is mainly present around the transcription start site of genes and has been linked to activation of nuclear hormone receptors. SIRT7 thereby acts as a transcription repressor. Moreover, H3K18 hypoacetylation has been reported as a marker of malignancy in various cancers and seems to maintain the transformed phenotype of cancer cells. These data suggest that SIRT7 may play a key role in oncogenic transformation by suppresses expression of tumor suppressor genes by locus-specific deacetylation of H3K18Ac at promoter regions. Also required to restore the transcription of ribosomal RNA (rRNA) at the exit from mitosis: promotes the association of RNA polymerase I with the rDNA promoter region and coding region. Stimulates transcription activity of the RNA polymerase I complex. May also deacetylate p53/TP53 and promotes cell survival, however such data need additional confirmation.
Related Products / Services
Please note: All products are "FOR RESEARCH USE ONLY AND ARE NOT INTENDED FOR DIAGNOSTIC OR THERAPEUTIC USE"
